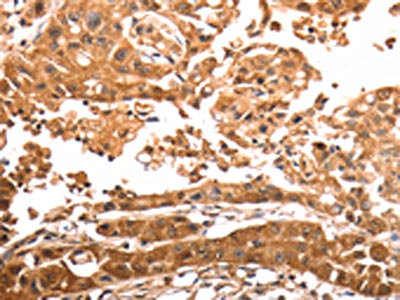

SLC39A6 Antibody
-
中文名稱:SLC39A6兔多克隆抗體
-
貨號:CSB-PA559833
-
規(guī)格:¥1100
-
圖片:
-
The image on the left is immunohistochemistry of paraffin-embedded Human cervical cancer tissue using CSB-PA559833(SLC39A6 Antibody) at dilution 1/30, on the right is treated with synthetic peptide. (Original magnification: ×200)
-
The image on the left is immunohistochemistry of paraffin-embedded Human lung cancer tissue using CSB-PA559833(SLC39A6 Antibody) at dilution 1/30, on the right is treated with synthetic peptide. (Original magnification: ×200)
-
Gel: 10%SDS-PAGE, Lysate: 60 μg, Lane: Human colon cancer tissue, Primary antibody: CSB-PA559833(SLC39A6 Antibody) at dilution 1/500, Secondary antibody: Goat anti rabbit IgG at 1/8000 dilution, Exposure time: 5 minutes
-
-
其他:
產(chǎn)品詳情
-
Uniprot No.:
-
基因名:
-
別名:SLC39A6; LIV1; ZIP6; Zinc transporter ZIP6; Estrogen-regulated protein LIV-1; Solute carrier family 39 member 6; Zrt- and Irt-like protein 6; ZIP-6
-
宿主:Rabbit
-
反應(yīng)種屬:Human,Mouse,Rat
-
免疫原:Synthetic peptide of Human SLC39A6
-
免疫原種屬:Homo sapiens (Human)
-
標記方式:Non-conjugated
-
抗體亞型:IgG
-
純化方式:Antigen affinity purification
-
濃度:It differs from different batches. Please contact us to confirm it.
-
保存緩沖液:-20°C, pH7.4 PBS, 0.05% NaN3, 40% Glycerol
-
產(chǎn)品提供形式:Liquid
-
應(yīng)用范圍:ELISA,WB,IHC
-
推薦稀釋比:
Application Recommended Dilution ELISA 1:2000-1:10000 WB 1:500-1:2000 IHC 1:50-1:200 -
Protocols:
-
儲存條件:Upon receipt, store at -20°C or -80°C. Avoid repeated freeze.
-
貨期:Basically, we can dispatch the products out in 1-3 working days after receiving your orders. Delivery time maybe differs from different purchasing way or location, please kindly consult your local distributors for specific delivery time.
-
用途:For Research Use Only. Not for use in diagnostic or therapeutic procedures.
相關(guān)產(chǎn)品
靶點詳情
-
功能:May act as a zinc-influx transporter.
-
基因功能參考文獻:
- ZIP6 deficiency disturbs intracellular Zn2+ homeostasis, leading to increased cell survival in hypoxia and reduced E-cadherin expression, indicating that decreased ZIP6 expression is strongly associated with resistance to hypoxia. PMID: 28833062
- SLC39A6 promotes aggressiveness of esophageal carcinoma cells by increasing intracellular levels of zinc, activating phosphatidylinositol 3-kinase signaling, and up-regulating genes that regulate metastasis. PMID: 28209530
- Upregulation of SLC39A6 is associated with hepatocellular carcinoma. PMID: 26684241
- SLC39A6 may have a tumor promoting role in esophageal carcinoma PMID: 26444413
- Knock-down of ZIP6 but not ZIP7 in MIN6 beta cells impaired the protective effects of GLP-1 on fatty acid-induced cell apoptosis, possibly via reduced activation of the p-ERK pathway PMID: 25969539
- drug resistance of ovarian cancer cells to trichostatin A may be related to expression of the LIV1 gene PMID: 25420545
- Zinc and its transporters, ZIP6 and ZIP10, are required for the breast cancer cells motility stimulated with high glucose level, such as in diabetes. PMID: 24587242
- a causative role for ZIP6 in cell motility and migration PMID: 23919497
- Down-regulated LIV-1 cells showed significant inhibition of proliferation in vitro and reduction of tumor growth in vivo. Furthermore, E-cadherin expression increased in LIV-1 siRNA expressing Hep-G2. PMID: 23437163
- SLC39A6 has an important role in the prognosis of esophageal squamous-cell carcinoma and may be a potential therapeutic target. PMID: 23644492
- Some studies correlate LIV-1 expression with a more aggressive cancer phenotype and increased likelihood for metastasis to lymph nodes. In contrast, other evidence suggests this transporter is associated with a more favorable prognosis. [review] PMID: 22852056
- The results of this study showed evidence for a positive correlation between LIV1 and ZnT6 insuperior temporal, occipital, and frontal gyri in patient with alzheimer disease. PMID: 22349685
- LIV-1 is involved in prostate cancer progression as an intracellular target of growth factor receptor signaling which promoted EMT and cancer metastasis PMID: 22110740
- LIV-1 mRNA upregulation is associated with the progression of cervical cancer but not with the development of endometrial carcinoma. PMID: 17959546
- The present study identifies LIV1 as a critical mediator responsible for HDACi-induced apoptosis. The effect of LIV1 is, at least in part, mediated by affecting intracellular zinc homeostasis. PMID: 19887557
- Zip6 over-expression is not an underlying mechanism initiating breast cancer, but in fact may play a "tumor-constraining" role. PMID: 19852955
- Structure-function analysis of LIV-1. PMID: 12839489
- data suggest that LIV-1 protein is a promising candidate for a novel marker for breast cancer patients with better outcome PMID: 15986450
- regulation of LIV-1 protein in human breast cancer xenografts PMID: 17786585
- Hence, our data provide the first evidence that LIV-1 mRNA is overexpressed in cervical cancer in situ and is involved in invasion of cervical cancer cells through targeting MAPK-mediated Snail and Slug expression. PMID: 17825787
- LIV-1 may be a regulator of E-cadherin PMID: 18330719
- Single nucleotide polymorphism in SLC39A6 gene is associated with acute lymphoblastic leukemia. PMID: 19066393
- LIV-1 enhances the aggressive phenotype through the induction of epithelial to mesenchymal transition in human pancreatic carcinoma cells. PMID: 19724917
- LIV-1 co-clusters with estrogen receptor alpha in microarray analysis of breast cancer biopsies. PMID: 11911440
- Review of LIV-1 and other LZT proteins. PMID: 12659941
- LIV-1, a member of the ZIP family of zinc transporters, is an integral plasma membrane protein that transports zinc into cells. PMID: 12839489
- LIV-1 is coregulated with estrogen receptor in some breast cancers. PMID: 12960427
顯示更多
收起更多
-
亞細胞定位:Cell membrane; Multi-pass membrane protein.
-
蛋白家族:ZIP transporter (TC 2.A.5) family
-
組織特異性:Highly expressed in the breast, prostate, placenta, kidney, pituitary and corpus callosum. Weakly expressed in heart and intestine. Also highly expressed in cells derived from an adenocarcinoma of the cervix and lung carcinoma.
-
數(shù)據(jù)庫鏈接:
Most popular with customers
-
-
YWHAB Recombinant Monoclonal Antibody
Applications: ELISA, WB, IHC, IF, FC
Species Reactivity: Human, Mouse, Rat
-
Phospho-YAP1 (S127) Recombinant Monoclonal Antibody
Applications: ELISA, WB, IHC
Species Reactivity: Human
-
-
-
-
-